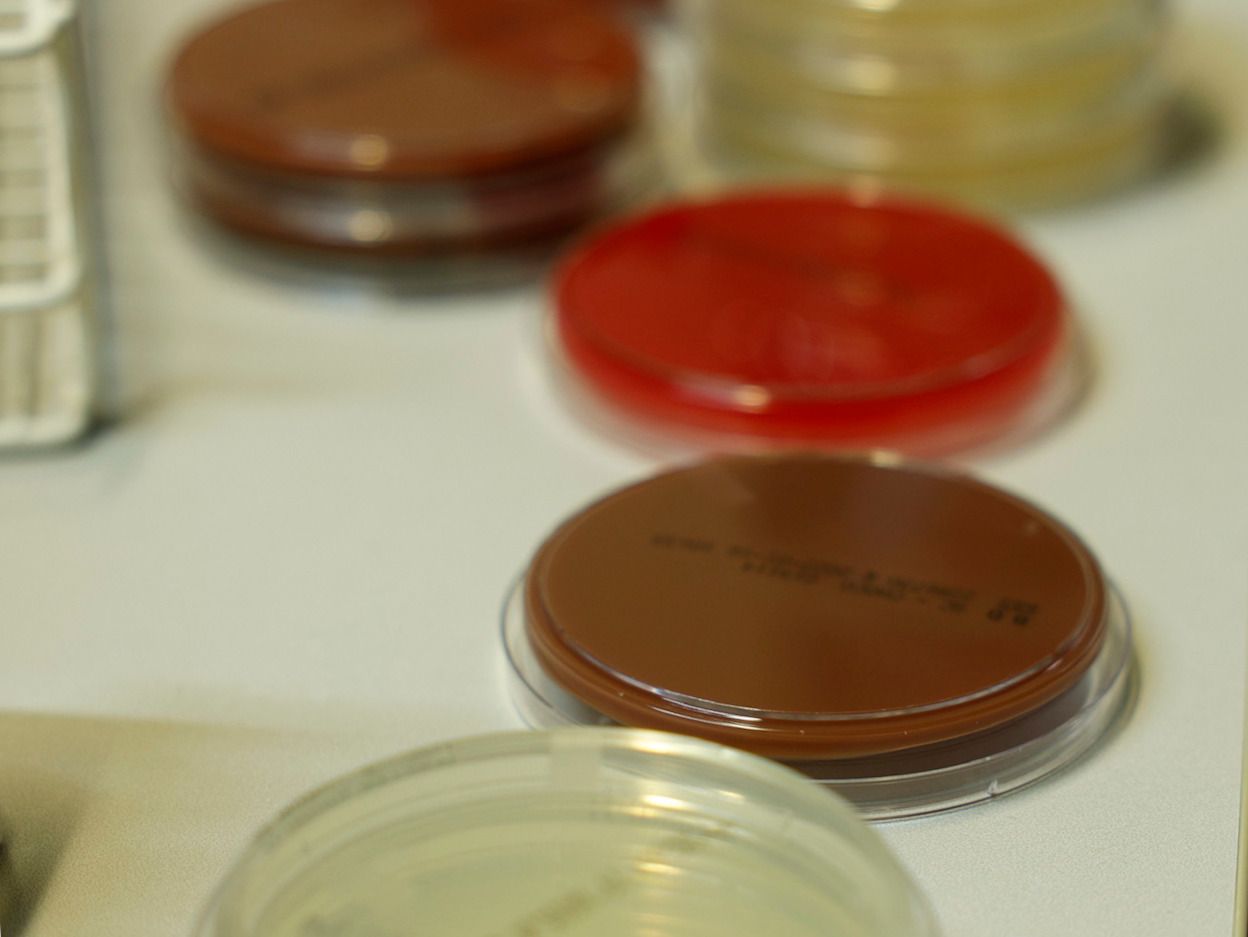

Laborleistungen für Mikrobiologie, Virologie und Infektionsserologie
In unseren modernen Laborräumen mit hochqualifizierten Mitarbeitern führen wir diagnostische Untersuchungen im Bereich der Mikrobiologie und Virologie mit kulturellen und molekularbiologischen Methoden durch.
- Kulturelle und/oder molekularbiologische Diagnostik sämtlicher Untersuchungsmaterialien
- Diagnostik von multiresistenten Keimen (Screening, Therapie, evtl. Sanierung)
- MRSA (Multiresistenter Staphylococcus aureus)
- MRGN (Multiresistente gramnegative Bakterien)
Einer unserer Schwerpunkte ist die Diagnostik von Infektionen in der Gynäkologie und Urologie
- Blasenentzündung
- Urethritis
- Prostatitis
- STI (Sexually Transmitted Infections)
- Bakterielle Vaginose
Wir bieten auch ein breites Portfolio an infektionsserologischen Untersuchungen an. Bei vielen Infektionskrankheiten kann die Diagnostik nur indirekt, mittels Untersuchung der Antikörper im Blut, erfolgen.
Hier liegt unser Schwerpunkt in der Diagnostik der Borreliose und anderer zeckenübertragenen Infektionen.
- Borreliose
- Infektassoziierte Arthritiden
Zu den Blutuntersuchungen gehören auch die Rheumaserologie und die Autoimmundiagnostik.
- Rheumafaktoren
- CCP-Antikörper
- ANA (Antinukleäre Antikörper)
Bei der Allergiediagnostik untersuchen wir auf eine Vielzahl von Nahrungsmittel-, Inhalations- und Insektenallergenen.